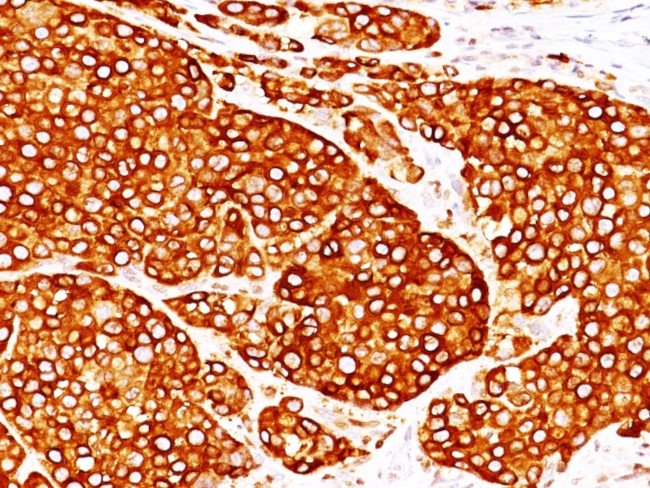
Tyrosinase (Melanoma Marker) Antibody in Immunohistochemistry (Paraffin) (IHC (P))

Search
NeoBiotechnologies
Tyrosinase (Melanoma Marker) Monoclonal Antibody (T311, OCA1/812)
{{$productOrderCtrl.translations['antibody.pdp.commerceCard.promotion.promotions']}}
{{$productOrderCtrl.translations['antibody.pdp.commerceCard.promotion.viewpromo']}}
{{$productOrderCtrl.translations['antibody.pdp.commerceCard.promotion.promocode']}}: {{promo.promoCode}} {{promo.promoTitle}} {{promo.promoDescription}}. {{$productOrderCtrl.translations['antibody.pdp.commerceCard.promotion.learnmore']}}
产品信息
7299-MSM3-P0
种属反应
宿主/亚型
分类
类型
克隆号
抗原
偶联物
形式
浓度
规格
纯化类型
保存液
内含物
保存条件
运输条件
靶标信息
The enzyme encoded by this gene catalyzes the first 2 steps, and at least 1 subsequent step, in the conversion of tyrosine to melanin. The enzyme has both tyrosine hydroxylase and dopa oxidase catalytic activities, and requires copper for function. Mutations in this gene result in oculocutaneous albinism, and nonpathologic polymorphisms result in skin pigmentation variation. The human genome contains a pseudogene similar to the 3' half of this gene.
仅用于科研。不用于诊断过程。未经明确授权不得转售。
篇参考文献 (0)
生物信息学
蛋白别名: LB24-AB; Monophenol monooxygenase; oculocutaneous albinism IA; SK29-AB; Tumor rejection antigen AB; Tyrosinase; tyrosinase precursor (EC 1.14.18.1)
基因别名: ATN; CMM8; OCA1; OCA1A; OCAIA; SHEP3; TYR
UniProt ID: (Human) P14679
Entrez Gene ID: (Human) 7299